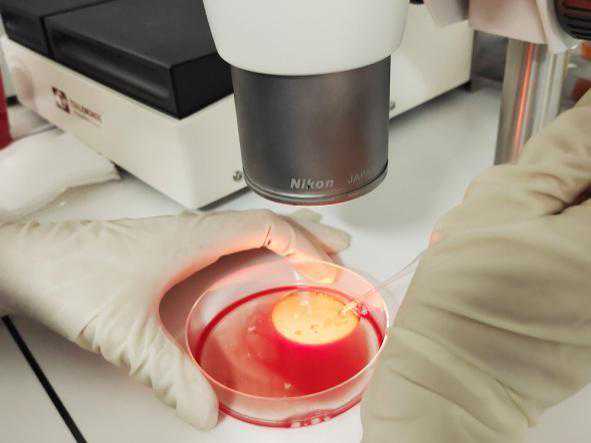

1978年7月25日,世界上第一例试管婴儿出生。为了肯定胚胎学家对辅助生殖医学所做出的贡献,每年的7月25日被定义为“世界胚胎学家日”。
体外受精-胚胎移植技术,俗称“试管婴儿”。是将不孕夫妇的精子和卵子,在体外完成受精和胚胎的早期发育,再将胚胎移植回女性子宫内发育至足月分娩的过程。
而卵子和精子结合受精并形成早期胚胎的这个过程是在IVF胚胎实验室里进行,胚胎实验室是生殖中心最核心、最神秘、最温暖的生命腹地,亦被喻为生殖中心的“心脏”。
在这里,有着一群人探索着“生命起始奥秘”;他们在黑暗的环境下,靠着微弱的灯光,细心呵护着不孕不育家庭的希望;他们,就是试管婴儿幕后的英雄——胚胎学家。
那么,在你眼中的胚胎实验室又是怎样的一个地方呢?胚胎学家们每天都做些什么呢?我们一起走进东莞首批开展试管婴儿技术的医疗机构——东莞广济医院生殖中心的胚胎实验室去了解一下吧~
广济生殖中心胚胎实验室

东莞广济医院生殖中心胚胎实验室设备先进,管理严格规范,每一位胚胎学家均经过严格培训考核上岗,不合格不上岗,具备严谨的工作态度,经过规范化培训,严格执行操作规程,保证了实验室的安全和稳定。目前该中心胚胎实验室胚胎解冻复苏率平均值在99%以上。
至今已开展第一代、第二代试管婴儿及夫精人工授精等相关技术,其中包括捡卵、常规体外受精、卵胞浆内单精子注射技术、移植、辅助孵化、胚胎玻璃化冷冻解冻技术、精子冷冻及解冻技术、精子优化处理、卵子激活等。
实验室团队有胚胎实验室主任1名,副主任1名,胚胎学家5名,其中硕士研究生1名,本科6名。胚胎学家工作经验丰富,技术过硬。全体胚胎学家的共同愿望是“给我一份信任,还您一份满意!”
精液处理
他们仔细核实患者身份信息,信息核对把控严谨。


捡卵
捡卵时,直视显微镜的强光,速度与精确并存,减少卵子在培养箱外暴露的时间。

授精
授精时,为了把握精卵结合的最佳时刻,计算授精时间,调整精子密度。
拆卵
精细的操作容不得他们有一丝一毫的怠慢。

观察胚胎
在显微镜下仔细观察胚胎发育情况,同时进行胚胎评分及评估。

胚胎移植
关键的一步离不开他们的“巧手”。

胚胎冷冻
在显微镜下把发育较好的胚胎进行冷冻保存。



胚胎学家们岗位分工明确,工作精细,不允许出现一丝一毫的失误与差错,他们与临床医生一起肩负着帮助每个家庭实现抱婴梦想的使命。
今天是世界胚胎学家日,祝全世界的胚胎学家们节日快乐,也向试管婴儿的幕后英雄们道一声:您辛苦了!